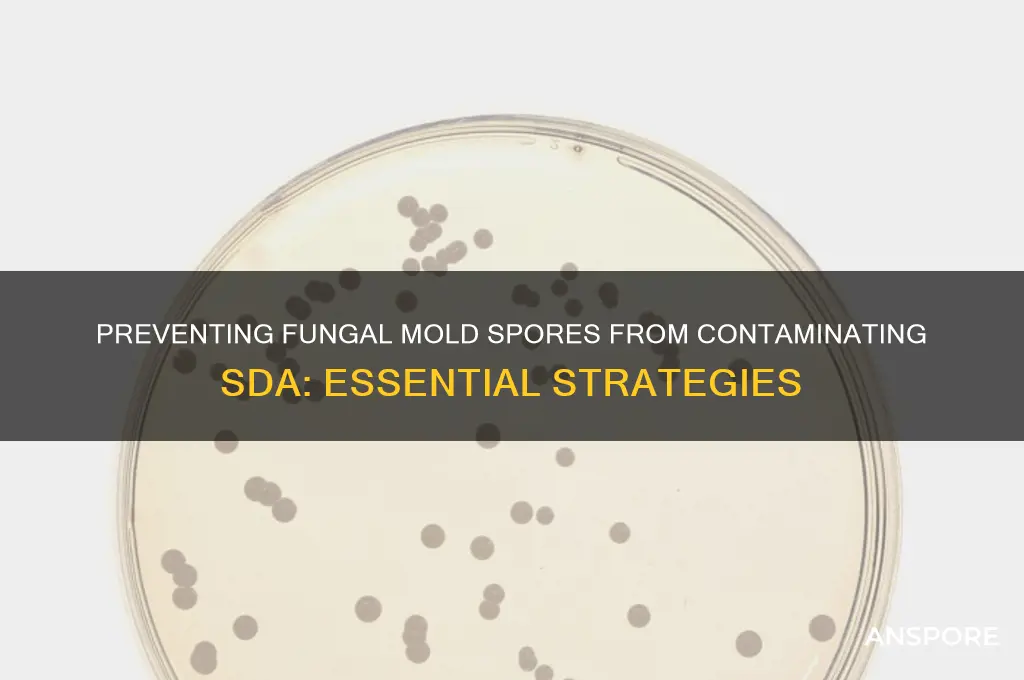
how can fungal mold spores contamine the sda

Fungal mold spores pose a significant risk of contaminating Sabouraud Dextrose Agar (SDA), a commonly used medium for cultivating fungi, due to their ubiquitous presence in the environment and their ability to remain viable under a wide range of conditions. These microscopic spores can easily become airborne, settling on surfaces, including laboratory equipment and SDA plates, during preparation, incubation, or handling. Once introduced, mold spores can rapidly germinate and grow on SDA, outcompeting target fungi and compromising the accuracy of diagnostic or research results. Contamination can occur through inadequate sterilization techniques, improper aseptic practices, or exposure to contaminated environments, highlighting the need for stringent protocols to minimize fungal spore intrusion in microbiological work.
Explore related products
What You'll Learn
- Airborne Transmission: Spores travel through air, settling on SDA plates, leading to contamination during incubation
- Surface Contact: Contaminated lab surfaces transfer spores to SDA via hands or tools
- Improper Sterilization: Inadequate sterilization of equipment allows spores to survive and grow on SDA
- Media Preparation: Poorly prepared SDA (e.g., unfiltered or overheated) may contain viable spores
- Environmental Exposure: Open SDA plates in mold-prone environments risk spore contamination from surroundings

Airborne Transmission: Spores travel through air, settling on SDA plates, leading to contamination during incubation
Fungal mold spores are microscopic, lightweight, and easily dispersed through the air, making them a significant risk for contaminating Sabouraud Dextrose Agar (SDA) plates during incubation. These spores can remain suspended in the air for extended periods, traveling through laboratory spaces and settling on exposed surfaces, including SDA plates. Once settled, they germinate under favorable conditions, leading to visible mold colonies that compromise the integrity of microbiological cultures. This airborne transmission is particularly insidious because it can occur even in seemingly controlled environments, highlighting the need for stringent aseptic techniques and environmental monitoring.
To mitigate airborne contamination, laboratories must implement proactive measures. First, ensure SDA plates are only opened within a sterile laminar flow hood, which provides a HEPA-filtered environment to minimize spore exposure. Plates should be handled with sterile tools, and technicians must wear appropriate personal protective equipment, including lab coats, gloves, and masks, to reduce the release of spores from clothing or skin. Additionally, incubators should be regularly cleaned and disinfected, as spores can accumulate on internal surfaces and recirculate during incubation. Maintaining a clean laboratory environment, including frequent wiping of surfaces with fungicidal agents, is equally critical to reducing airborne spore counts.
A comparative analysis of contamination rates in labs with and without air quality control systems underscores the importance of environmental management. Labs equipped with HEPA filtration and positive pressure systems report significantly lower contamination rates compared to those relying solely on standard ventilation. For example, a study found that labs with HEPA filtration had a contamination rate of 5% versus 20% in labs without such systems. This data emphasizes the role of air quality in preventing spore transmission and suggests that investing in advanced filtration systems can yield substantial improvements in culture purity.
Practical tips for minimizing airborne contamination include timing incubation periods to avoid peak spore release times, such as early morning or after lab cleaning activities. Incubators should be placed away from high-traffic areas or sources of air disturbance, like open windows or doors. For high-risk experiments, consider using sealed incubation chambers or anaerobic jars to create a physical barrier against airborne spores. Regularly inspect SDA plates for early signs of contamination, such as discoloration or fuzzy growth, and discard affected plates immediately to prevent spore release back into the environment.
In conclusion, airborne transmission of fungal mold spores poses a persistent threat to SDA plate integrity, but it can be managed through a combination of environmental control, aseptic technique, and proactive monitoring. By understanding the behavior of spores and implementing targeted interventions, laboratories can significantly reduce contamination rates and ensure the reliability of microbiological analyses. This approach not only safeguards experimental results but also promotes a safer, more efficient laboratory workflow.
Equinox's Abilities: Can They Proc Saryn's Spores in Warframe?
You may want to see also

Surface Contact: Contaminated lab surfaces transfer spores to SDA via hands or tools
Fungal mold spores are microscopic and ubiquitous, making them a persistent threat to the integrity of laboratory cultures, particularly Sabouraud Dextrose Agar (SDA). Surface contact is a primary vector for contamination, as spores can adhere to lab surfaces and transfer to SDA via hands or tools. Understanding this pathway is crucial for implementing effective preventive measures.
Steps to Mitigate Surface Contamination:
- Regular Disinfection: Use 70% ethanol or a 10% bleach solution to clean workbenches, pipettes, and other tools before and after use. Allow surfaces to air-dry to ensure residual disinfectant evaporates completely.
- Designated Zones: Establish separate areas for pre- and post-inoculation tasks to minimize cross-contamination. For example, prepare SDA plates in a clean zone and incubate them in a designated growth area.
- Personal Protective Equipment (PPE): Wear nitrile gloves and change them frequently, especially after handling contaminated materials or touching surfaces outside the sterile zone.
Cautions to Consider:
Avoid over-reliance on gloves as a sole barrier. Spores can accumulate on glove surfaces, transferring to SDA if gloves are not changed or disinfected. Additionally, do not use aerosolized disinfectants near open cultures, as this can introduce airborne spores.
Practical Tips for High-Risk Labs:
In environments with high fungal spore loads (e.g., mycology labs), use disposable tools whenever possible. For reusable equipment, autoclave at 121°C for 15–20 minutes to ensure spore inactivation. Train personnel to adopt a "touchless" approach, minimizing direct contact with surfaces during critical steps.
Surface contact is a silent yet significant contributor to SDA contamination. By adopting rigorous disinfection protocols, maintaining spatial organization, and leveraging appropriate PPE, labs can drastically reduce the risk of fungal spore transfer. Vigilance and consistency in these practices are key to preserving the accuracy of microbiological analyses.
Understanding Spores: Their Role, Survival Mechanisms, and Ecological Impact
You may want to see also

Improper Sterilization: Inadequate sterilization of equipment allows spores to survive and grow on SDA
Fungal mold spores are remarkably resilient, capable of surviving harsh conditions that would destroy most microorganisms. When equipment used in microbiological work—such as petri dishes, pipettes, or culture tubes—is not properly sterilized, these spores can persist, leading to contamination of Sabouraud Dextrose Agar (SDA). This contamination not only compromises experimental results but also poses risks in clinical and industrial settings where accurate fungal isolation is critical.
Steps to Prevent Contamination Through Sterilization:
- Autoclaving: Ensure all equipment is autoclaved at 121°C for at least 15 minutes. This temperature and duration are sufficient to kill fungal spores, which are more heat-resistant than bacterial spores.
- Chemical Sterilization: For heat-sensitive equipment, use a 70% ethanol solution or a 2% glutaraldehyde solution. Allow contact time of at least 10 minutes to ensure spore inactivation.
- Flame Sterilization: For metal tools like inoculating loops, flame sterilization is effective. Pass the tool through a Bunsen burner flame until it glows red, then allow it to cool before use.
Cautions in Sterilization Practices:
Inadequate sterilization often results from shortcuts, such as reducing autoclave cycle times or using insufficient concentrations of chemical sterilants. For instance, using a 50% ethanol solution instead of 70% may fail to kill fungal spores. Additionally, overloading the autoclave can prevent proper steam penetration, leaving spores intact. Always verify sterilization efficacy using biological indicators, such as *Geobacillus stearothermophilus* spores, which are more resistant than fungal spores.
Analyzing the Impact of Improper Sterilization:
When fungal spores survive sterilization, they germinate on SDA, a medium specifically designed to support fungal growth. This leads to false-positive results in experiments or misdiagnosis in clinical labs. For example, a study in a mycology lab found that 30% of contaminated SDA plates were due to improperly sterilized pipettes. Such errors can delay research, increase costs, and compromise patient care in diagnostic settings.
Practical Tips for Consistent Sterilization:
- Regularly maintain and calibrate autoclaves to ensure optimal performance.
- Train personnel on proper sterilization techniques and the importance of adhering to protocols.
- Use disposable equipment where possible to minimize the risk of spore carryover.
- Implement a checklist system to verify sterilization steps before and after use.
By addressing the root cause of improper sterilization, laboratories can significantly reduce the risk of fungal spore contamination on SDA, ensuring reliable results and maintaining the integrity of microbiological work.
Are Slime Mold Spores Harmful? Uncovering the Truth and Risks
You may want to see also
Explore related products
$13.48 $14.13

Media Preparation: Poorly prepared SDA (e.g., unfiltered or overheated) may contain viable spores
Fungal mold spores are ubiquitous in the environment, and their resilience makes them a persistent challenge in laboratory settings. When preparing Sabouraud Dextrose Agar (SDA), a medium commonly used for fungal cultivation, even minor lapses in technique can introduce viable spores, compromising the integrity of the culture. Poorly prepared SDA, whether due to inadequate filtration or overheating, becomes a breeding ground for contamination rather than a tool for isolation.
Consider the filtration step, a critical barrier against airborne spores. SDA prepared without proper filtration, such as using a sterile filter with a pore size larger than 0.22 microns, allows spores to pass through unchallenged. For instance, *Aspergillus* spores, ranging from 2 to 3 microns in size, can easily infiltrate unfiltered media. Even if the medium is autoclaved afterward, heat-resistant spores like those of *Talaromyces* may survive, rendering the SDA unusable for accurate fungal isolation.
Overheating SDA during preparation is another common pitfall. Heating the medium above 121°C or extending autoclaving beyond 15 minutes can degrade agar and nutrients, creating an environment conducive to spore survival. Overheated SDA often appears discolored or forms a skin, signaling chemical changes that favor fungal growth. For example, *Penicillium* species thrive in nutrient-depleted environments, making overheated SDA an ideal substrate for their proliferation.
To mitigate these risks, adhere to precise protocols. Filter sterilize SDA using a 0.22-micron filter before dispensing into plates, ensuring spore exclusion. Autoclave the medium at 121°C for 15 minutes, no longer, to maintain its integrity. Inspect prepared plates for signs of contamination, such as discoloration or surface irregularities, before use. By addressing these specific vulnerabilities in media preparation, laboratories can safeguard SDA against fungal mold spores, ensuring reliable results in mycological studies.
Understanding Spore Syringe Size: A Comprehensive Guide for Beginners
You may want to see also

Environmental Exposure: Open SDA plates in mold-prone environments risk spore contamination from surroundings
Fungal mold spores are ubiquitous in the environment, especially in areas with high humidity, poor ventilation, and organic matter. When working with Sabouraud Dextrose Agar (SDA) plates, a medium commonly used for fungal cultivation, the risk of contamination from these spores escalates in mold-prone environments. Opening SDA plates in such settings exposes them to airborne spores, which can settle on the agar surface and proliferate, compromising the integrity of the culture. This contamination not only wastes resources but also skews experimental results or diagnostic outcomes.
Consider a laboratory located in a tropical climate, where humidity levels often exceed 70%. In such conditions, mold spores thrive in the air and on surfaces. If an SDA plate is opened for inoculation or inspection, even briefly, it becomes a prime target for these spores. A study in *Applied Microbiology* found that exposure of open plates to ambient air for as little as 30 seconds in high-humidity environments resulted in detectable mold growth within 48 hours. This highlights the critical need for stringent aseptic techniques in mold-prone settings.
To mitigate this risk, implement a multi-step approach. First, designate a clean, low-humidity workspace for handling SDA plates. Use a biosafety cabinet or laminar flow hood to create a sterile environment, reducing the likelihood of spore infiltration. Second, minimize the duration SDA plates remain open. For instance, pre-prepare inoculation tools and work swiftly to limit exposure time. Third, monitor environmental conditions regularly. Hygrometers can measure humidity levels, and dehumidifiers can maintain optimal conditions below 50%. Lastly, adopt a routine sterilization protocol for work surfaces and equipment using 70% ethanol or a 10% bleach solution to eliminate residual spores.
Comparing this to less controlled environments underscores the importance of proactive measures. In a home laboratory or educational setting, where humidity control and sterile equipment may be limited, the risk of contamination is exponentially higher. For example, a high school biology classroom in a damp basement reported a 90% contamination rate in SDA plates used for student experiments, compared to a professional lab with controlled conditions, which maintained a contamination rate below 5%. This disparity emphasizes the need for tailored solutions based on the environment’s inherent risks.
In conclusion, environmental exposure to mold spores is a significant threat to SDA plate integrity, particularly in mold-prone settings. By understanding the mechanisms of contamination and implementing targeted strategies, such as controlled workspaces, minimized exposure times, and environmental monitoring, the risk can be substantially reduced. Whether in a professional lab or a makeshift workspace, vigilance and adaptability are key to preserving the accuracy and reliability of fungal cultures.
Ultraviolet Light vs. Mold Spores: Effective Solution or Myth?
You may want to see also
Frequently asked questions
Fungal mold spores can contaminate SDA through airborne transmission, where spores settle on the agar surface during preparation or incubation.
Yes, inadequate sterilization of Petri dishes, inoculating loops, or other tools can introduce fungal mold spores directly into the SDA.
Yes, leaving SDA plates exposed to the air for extended periods increases the likelihood of airborne fungal spores settling and growing on the agar.
Yes, using contaminated water or reagents during SDA preparation can introduce fungal mold spores into the medium.
Storing SDA plates in humid or unclean environments can promote fungal growth, leading to contamination when the plates are later used.

























